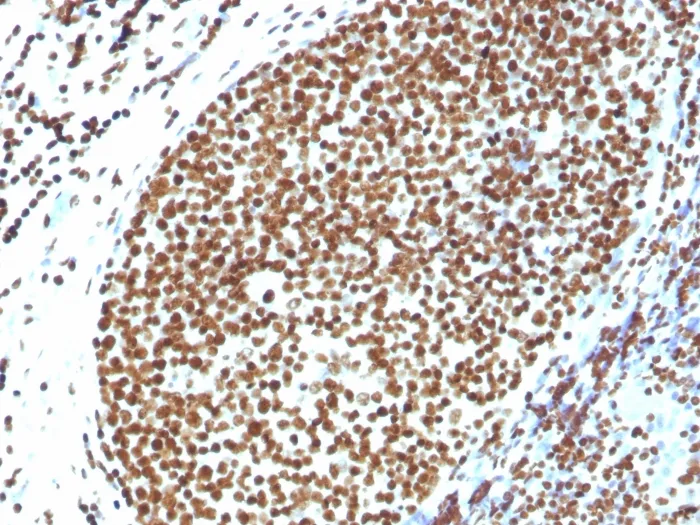
Anti-Histone H1 (Pan Nuclear Marker)(N/A), CF568 conjugate - image 1

Anti-Histone H1 (Pan Nuclear Marker)(N/A), CF568 conjugate
CAT:
37-BNC681816-100
Size:
100 µL
Price:
Ask
- Availability: 24/48H Stock Items & 2 to 6 Weeks non Stock Items.
- Dry Ice Shipment: No

Anti-Histone H1 (Pan Nuclear Marker)(N/A), CF568 conjugate
Description:
Eukaryotic histones are basic and water-soluble nuclear proteins that form hetero-octameric nucleosome particles by wrapping 146 base pairs of DNA in a left-handed super-helical turn sequentially to form chromosomal fiber. Two molecules of each of the four core histones (H2A, H2B, H3, and H4) form the octamer; formed of two H2A-H2B dimers and two H3-H4 dimers, forming two nearly symmetrical halves by tertiary structure. Over 80% of nucleosomes contain the linker Histone H1, derived from an intronless gene that interacts with linker DNA between nucleosomes and mediates compaction into higher order chromatin. Histones are subject to posttranslational modification by enzymes primarily on their N-terminal tails, but also in their globular domains. Such modifications include methylation, citrullination, acetylation, phosphorylation, sumoylation, ubiquitination and ADP-ribosylation. Primary antibodies are available purified, or with a selection of fluorescent CF® Dyes and other labels. CF® Dyes offer exceptional brightness and photostability. Note: Conjugates of blue fluorescent dyes like CF®405S and CF®405M are not recommended for detecting low abundance targets, because blue dyes have lower fluorescence and can give higher non-specific background than other dye colors.Synonyms:
HANP1; His1; HisC; HIST1; HIST1H1A; HIST1H1B; HIST1H1C; HIST1H1D; HIST1H1E; HIST1H1T; Oocyte-specific histone H1; Testicular H1 histoneUNSPSC:
41116161UNSPSC Description:
Primary and secondary antibodies for multiple methodology immunostaining detection applicationGene Name:
H1Gene ID:
3005NCBI Gene ID:
226117 & 97358UniProt:
MultipleCellular Locus:
NucleusHost:
RabbitSpecies Reactivity:
Human, Mouse, RatImmunogen:
Recombinant full-length human Histone H1 proteinTarget Antigen:
Histone H1Clonality:
PolyclonalIsotype:
IgGConjugation:
CF568Source:
AnimalApplications:
Flow, intracellular (verified) | IF (verified) | IHC, FFPE (verified) | WB (verified)Validated Applications:
FC, IF, IHC, FFPE, WBPositive Control:
HeLa, A-431, LNCap or Jurkat cells. Breast carcinoma.Concentration:
0.1 mg/mLBuffer:
PBS, 0.1% BSA, 0.05% azideMolecular Weight:
~30 kDaShipping Conditions:
Room temperatureStorage Conditions:
4°C; Protect from light; Stable at room temperature or 37°C (98°F) for 7 days.Shelf Life:
2 yearsCAS Number:
9007-83-4
DATASHEET Document
View DocumentMSDS Document
View Document